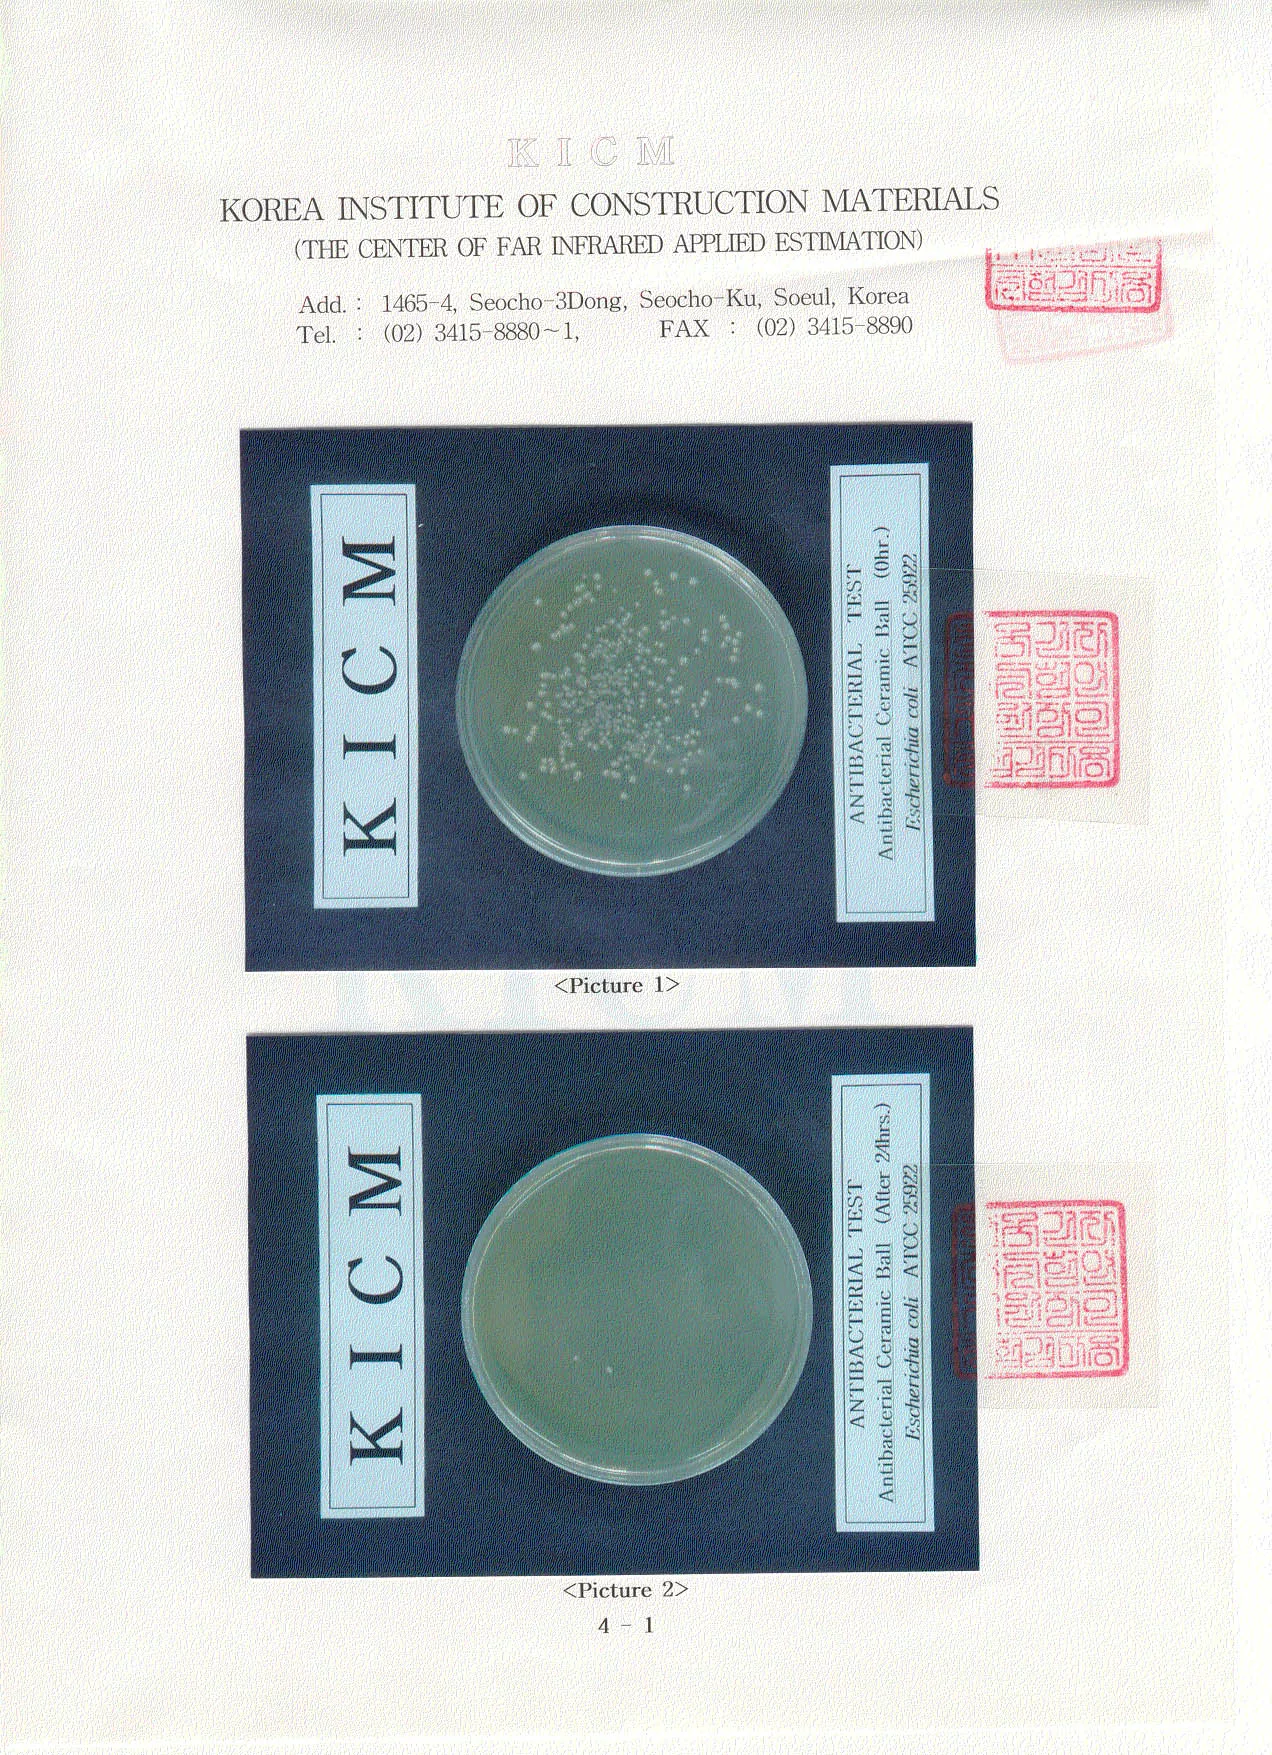
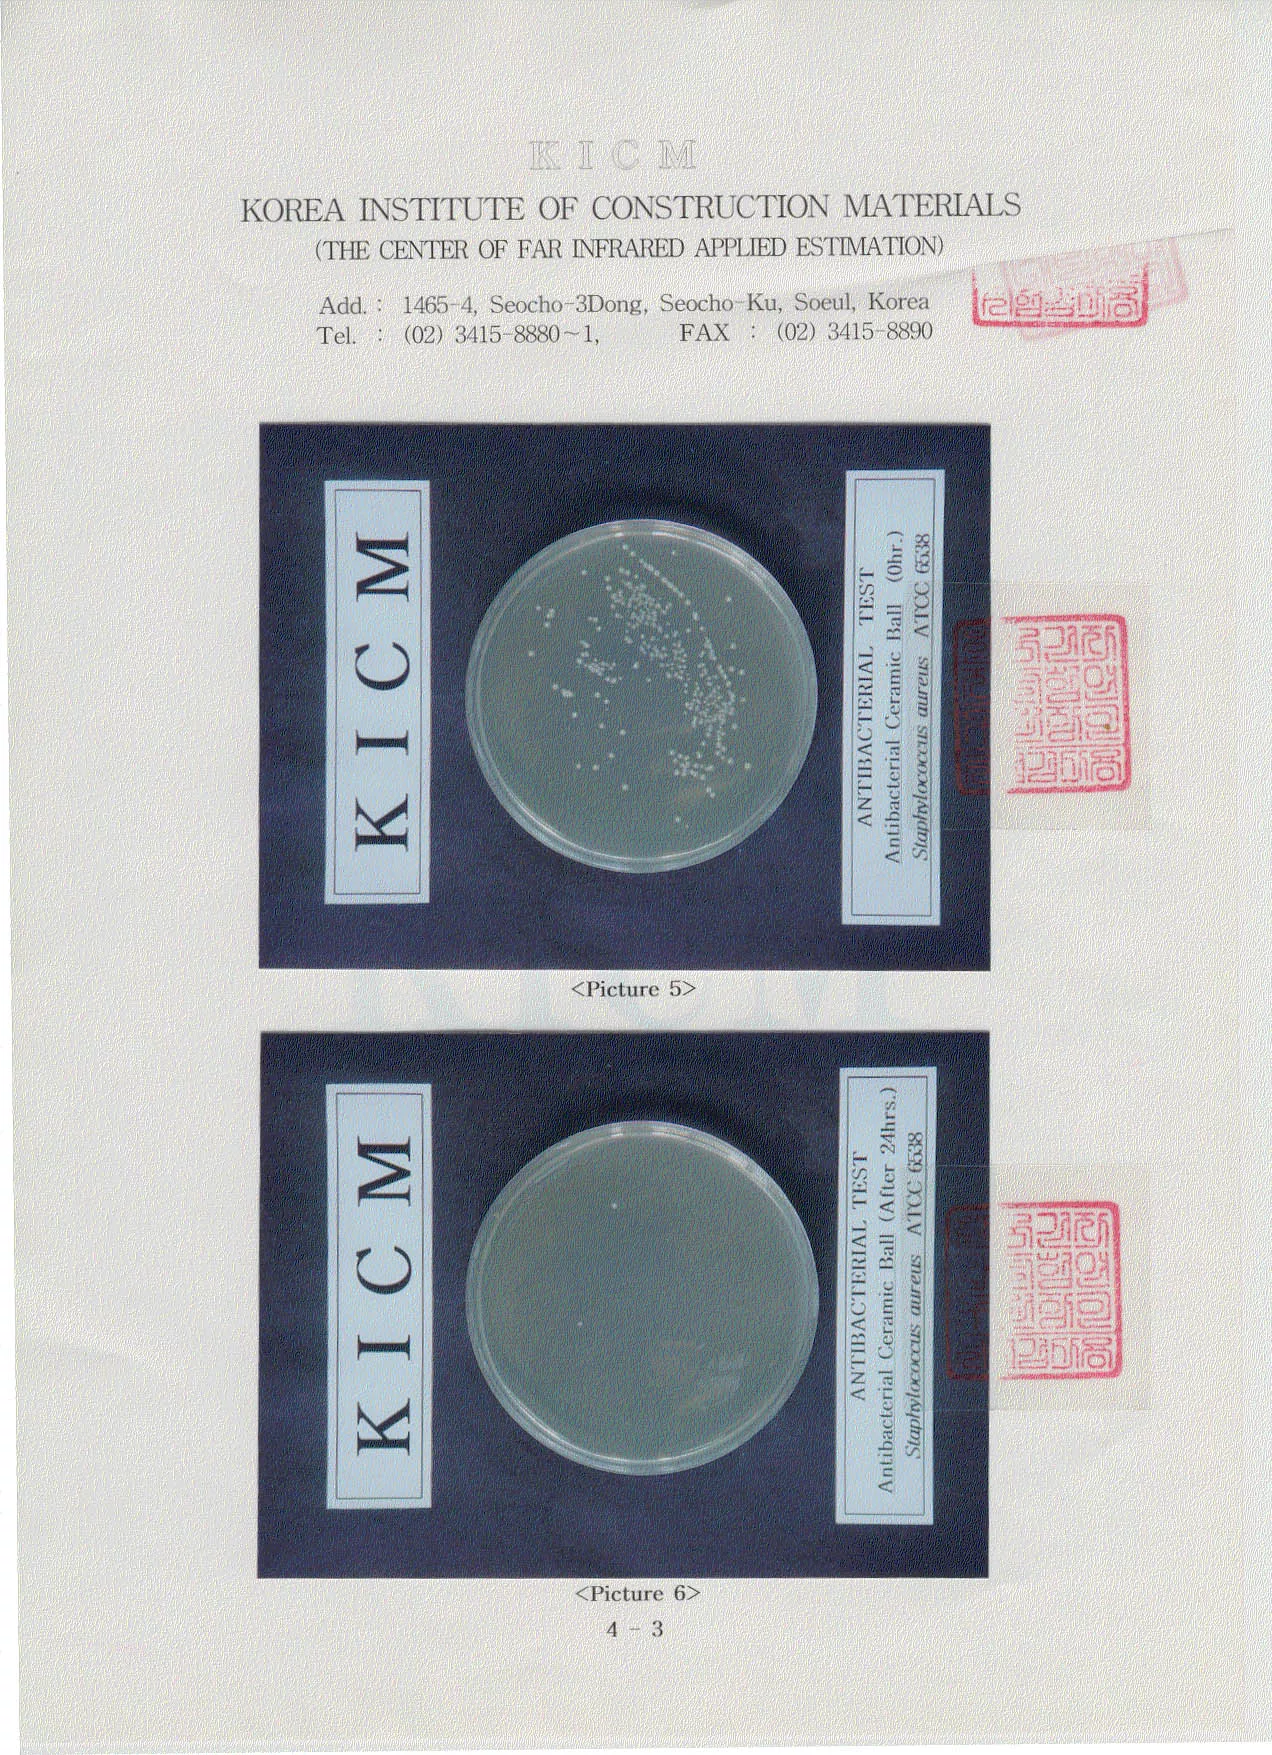
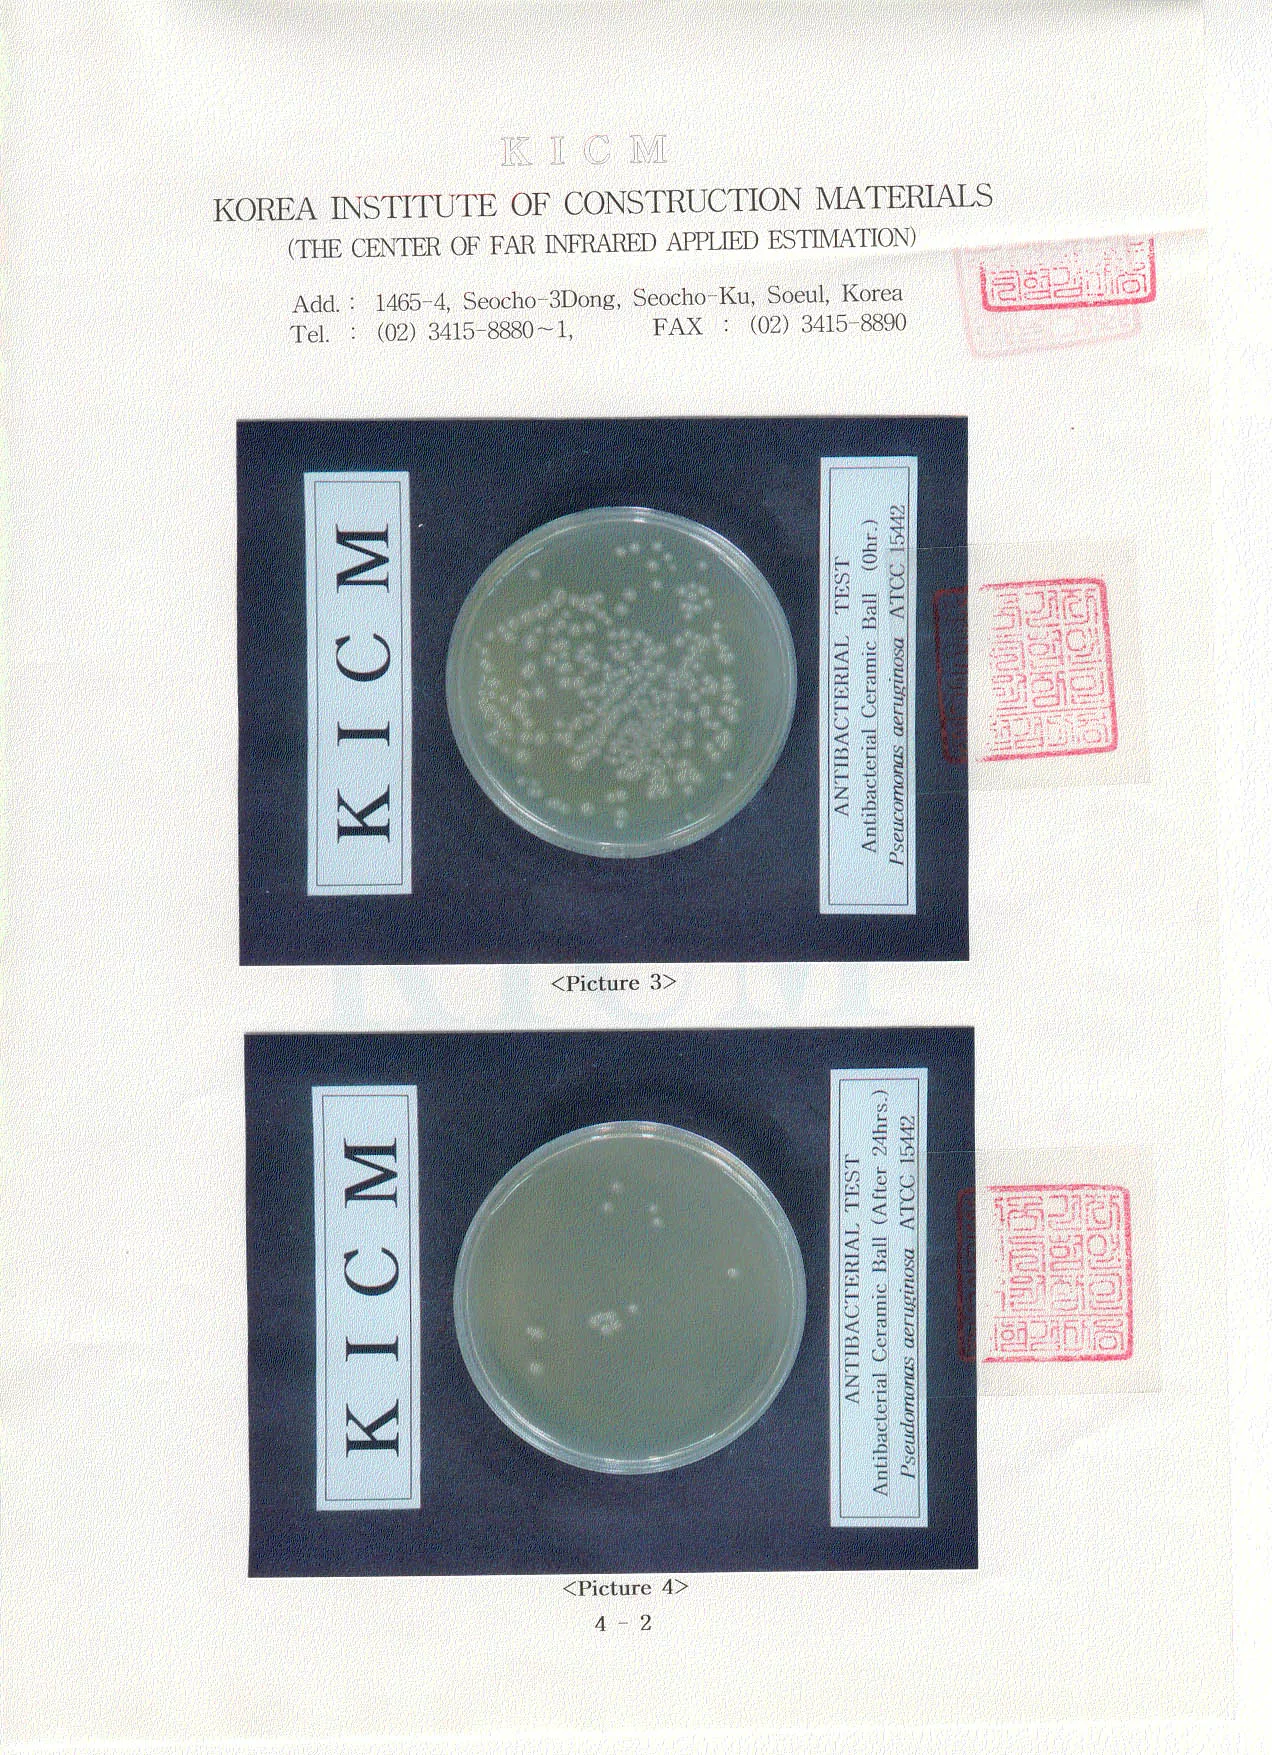

博客來e-coupon 水族,魚缸,養魚-生物陶瓷水質淨化珠(400g)
水族,魚缸,養魚-生物陶瓷水質淨化珠(400g)
水族,魚缸,養魚-生物陶瓷水質淨化珠(400g) 評價
網友滿意度:

最近愛上了運動~
可以瘦身雕塑身材又防老
一舉多得~~
但是運動要怎麼穿才能在運動揮灑汗水時又保持時尚
我推薦這件運動單品給大大
水族,魚缸,養魚-生物陶瓷水質淨化珠(400g)
我覺得優質運動服裝要時尚和舒適兼具 缺一不可
這件單品正符合我的需求
透氣.排汗.不磨皮膚~
是我運動時的好夥伴
在運動服裝選擇上的新手們
不仿可以參考看看我的建議
相信絕對不會讓你們後悔的~
老手們當然也可以參考一下呦~~~
大家一起動起來!!!!


水族,魚缸,養魚-生物陶瓷水質淨化珠(400g)
本週熱銷商品:
商品訊息功能:
商品訊息描述:
商品簡介

◆產品成分
天然礦石奈米化後以高溫高壓燒結成陶瓷球珠 (2013新配方)
◆主要功能
光觸媒 – 化解污垢
雙色瓷珠 – 抑止霉菌孳生、除臭、淨化水質、活化水質
◆使用說明
1.每100公克的生物陶瓷水質淨化珠適用5公升的水族缸,依各人水族缸的大小按比例使用。
2.水質淨化珠放入水族缸前,請先用清水沖洗掉瓷珠表面粉塵。
3.建議每兩個月將生物陶瓷水質淨化珠取出清洗,放置陽光下曬乾,再放回水族缸。
4.正常情況下使用,生物陶瓷水質淨化珠可使用2年。








商品訊息簡述:
- 定價:1200元
- 優惠價:1140元
水族,魚缸,養魚-生物陶瓷水質淨化珠(400g)

請先 登入 以發表留言。